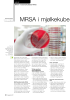
MRSA i mjølkekube setning

Alle mediene redigeres i henhold til
redaktørplakaten og vær varsom-plakaten.
redaktørplakaten og vær varsom-plakaten.
BUSKAP

BUSKAP er medlemsblad for Geno. Formålet er å være storfebondens fremste fagblad og å holde leserne oppdatert innen mjølke- og storfekjøttproduksjon. Redaksjonen legger vekt på leservennlighet og høyt faglig nivå på stoffet.
Antall lesere: 28 000 (Gallup Fagpresse 15.2)
Opplag: 12 321
Frekvens: 8 utgaver pr år
Ansvarlig redaktør
Rasmus Lang-Ree
95 02 06 00
rlr@geno.no
Annonseansvarlig
Aksel H. Belsvik-Karlsen
413 45 560
911 99 886
aksel@adapt-da.no
Utgiver:
Geno SA
Trykkeri:
07 Media AS
Artikler fra mediet

BUSKAP 30.01.2017

BUSKAP 30.01.2017

BUSKAP 30.01.2017

BUSKAP 30.01.2017

BUSKAP 30.01.2017

BUSKAP 30.01.2017

BUSKAP 30.01.2017

BUSKAP 30.01.2017
BUSKAP 30.01.2017

BUSKAP 30.01.2017
Sider
Nyhetsbrev
Lag ditt eget nyhetsbrev:




































































































